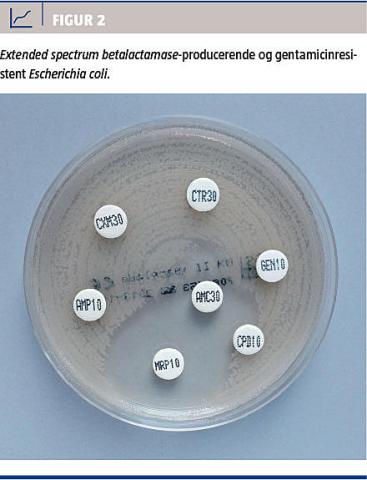

Ældre mennesker indlægges hyppigere og i længere tid ad gangen end yngre. De er dermed mere eksponerede for hospitalsassocierede patogener. De hyppigste hospitalsinfektioner hos ældre er urinvejsinfektioner, pneumoni og gastroenteritis. Nosokomielle infektionsrater angives at være på 7,6-10,6 pr. 100 sengedage hos ældre. Hyppigheden af hospitalserhvervede infektioner, herunder med multiresistente bakterier, og af multiple nosokomielle infektioner stiger med alderen [1, 2]. Da ældre oftere har komorbiditet, forringet organfunktion og nedsat immunitet, er deres prognose ved hospitalserhvervede infektioner dårligere end yngres. Mortalitetsrater blandt patienter med hospitalserhvervede infektioner angives at være på 14-43% på afdelinger for ældre.
Bakterier med resistens over for de mest brugte antibiotika spredes i samfundet og på sygehusene. Især Clostridium difficile, methicillinresistente Staphylococcus aureus (MRSA) og extended spectrum betalactamase (ESBL)-producerende Escherichia coli og Klebsiella pneumoniae får større betydning som årsag til komplikationer i forbindelse med hospitalsbehandling. Interventioner, bl.a. i form af ændringer i valg af antibiotika, kan reducere forekomsten af disse bakterier på hospitalerne [3, 4].
CLOSTRIDIUM DIFFICILE
C. difficile danner sporer, som er resistente over for desinfektion med alkohol (Figur 1). C. difficile-associeret sygdom (CDAD) skyldes toksinproducerende stammer og viser sig oftest som diaré. CDAD forekommer både på hospitaler og i samfundet og er associeret med behandling med smalspektrede såvel som bredspektrede antibiotika [5]. Hos indlagte patienter er CDAD en alvorlig sygdom og en markør for dårlig prognose: I Danmark er der fundet særdeles ringe etårsoverlevelser hos indlagte patienter med CDAD [6].

I en opgørelse fra USA fandt man i perioden 1999-2007 en femfolds forøgelse af mortaliteten, der var associeret til C. difficile. Alder over 65 år er en risikofaktor for at få CDAD, og alderen har stor indflydelse på forløbet af CDAD: Blandt patienter, der fik foretaget kolektomi pga. svær CDAD, var mortaliteten stærkt forøget hos patienterne over 80 år [7]. Det diskuteres, om samtidig infektion med norovirus øger spredningen af C. difficile, da der ses udbrud på hospitaler og plejehjem med begge patogener samtidigt [8].
Infektion med C. difficile af udbrudstypen 027 giver øget risiko for recidiv [9]. Blandt geriatriske patienter er helbredelsesfrekvensen lavere, og mortaliteten større ved denne type end ved non-027-typer [10]. I et udbrud med C. difficile-type 027 i Danmark i 2008-2009 var patienternes gennemsnitsalder 81 år [11].
Risikoen for recidiv af CDAD stiger med stigende alder [12-14]. Fækal transplantation er en ny og lovende recidivbehandling [15], der foreløbigt har vist godt resultat hos ældre [16].
CDAD efter udskrivelse fra hospital kan være en betydelig byrde for institutioner for ældre [17]. C. difficile spreder sig blandt beboere og besøgende på plejehjem, hvilket fører til nye tilfælde af CDAD og nye indlæggelser [18].
Hospitalserhvervet CDAD forlænger indlæggelsestiden [19] og medfører store omkostninger [20]. De årlige udgifter til behandling af primær CDAD har været estimeret til 800 mio. USD i USA og tre mia. euro i Europa [21].
EXTENDED SPECTRUM
BETALACTAMASE-PRODUCERENDE ENTEROBAKTERIER
Selvom stigningen i resistens for mange antibiotika hos E. coli og K. pneumoniae på det seneste har vist en stagnerende tendens, udgør cefalosporinresistente enterobakterier stadig et betydende problem [22].
E. coli og K. pneumoniae med ESBL-medieret cephalosporinresistens (Figur 2) isoleres hyppigt fra patienter i Danmark [23].
ESBL-producerende K. pneumoniae forårsager et stigende antal hospitalsudbrud [24]. Antibiotikaindtag op til 30 dage forud er blandt risikofaktorer for øget mortalitet hos ældre patienter, der har bakteriæmi med ESBL-producerende E. coli og K. pneumoniae [25].
METHICILLINRESISTENTE STAPHYLOCOCCUS AUREUS
I Danmark er nosokomiel smitte med MRSA nogenlunde konstant og ikke hyppig sammenlignet med smitte i samfundet, hvor der sker en kraftig stigning [22]. Samfundserhvervet MRSA kan spredes på hospitalerne [26], og MRSA kan spredes på plejehjem, som kan være kilder til MRSA på hospitalerne [27].
MRSA behandles i henhold til Sundhedsstyrelsens MRSA-retningslinjer [28]. Et vigtigt element er elimination af bærertilstand med chlorhexidinsæbe og mupirocinnæsesalve. Behandlingen forudsætter, at patienterne har intakt hud og ikke har katetre. Elimination af bærertilstand hos ældre er ofte forbundet med store udfordringer, da de ofte har kroniske sår og urinvejskatetre. Disse ældre er kroniske bærere af MRSA, og der kan være store udfordringer i at forebygge smittespredning på plejehjem uden at stigmatisere dem.
BEGRÆNSNING AF HOSPITALSINFEKTIONER
HOS ÆLDRE
En koordineret og ensartet infektionshygiejnisk indsats er særlig vigtig for ældre borgere, som ofte har hyppige kontakter til hospitalsvæsenet samt behov for hjemmepleje eller ophold i plejeinstitutioner. For disse borgere bliver sondringen mellem samfundserhvervet og nosokomiel infektion abstrakt, hvilket giver særlige udfordringer med hensyn til spredningsforebyggelse. Siden kommunalreformen i 2007 har samarbejdet mellem kommunerne og de infektionshygiejniske enheder på hospitalerne været udfordret af, at ikke alle kommuner tilkøber rådgivning fra de etablerede enheder på hospitalerne [29]. Sundhedsstyrelsen har med udgivelse af forebyggelsespakken om hygiejne til kommunerne i 2012 ønsket at understøtte det tværsektorielle samarbejde på dette område [30].

KONKLUSION
Hospitalserhvervede infektioner hos ældre er en kilde til betragtelig morbiditet og mortalitet, hvilket belaster den enkelte patient, hele sundhedssektoren og samfundsøkonomien.
Transmission af patogener mellem hospitaler og plejehjem udgør en særlig udfordring, da der ofte er gentagne indlæggelsesforløb.
Selv om infektionerne kan knyttes til biologiske faktorer hos ældre patienter, er der mulighed for en øget forebyggende indsats. En rationel antibiotikaanvendelse og en samlet tværsektoriel hygiejneindsats, der er skræddersyet til de individuelle patientforløb, kan bidrage til at stoppe smittespredning med de resistente bakterier, som volder størst problemer.
Korrespondance: Michael Kemp, Klinisk Mikrobiologisk Afdeling, Odense Universitetshospital, Sdr. Boulevard 29, 5000 Odense. E-mail: michael.kemp@rsyd.dk
Antaget: 5. november 2013
Interessekonflikter:
<h2>Litteratur</h2>
<ol type="d">
<li><p>Paillaud E, Herbaud S, Caillet P et al. Relations between undernutrition and<br> nosocomial infections in elderly patients. Age Ageing 2005;34:619-25.</p></li>
<li><p>Ho P-L, Wong RCW, Yip K-S et al. Antimicrobial resistance in Escherichia coli outpatient urinary isolates from women: emerging multidrug resistance phenotypes. Diagn Microbiol Infect Dis 2007;59:439-45. </p></li>
<li><p>Andersen SE, Knudsen JD, Stangerup M et al. A managed multidisciplinary programme on multi-resistant Klebsiella pneumoniae in a Danish university hospital. BMJ Qual Saf doi:10.1136/bmjqs-2012-001791 </p></li>
<li><p>Piacenti FJ, Leuthner KD. Antimicrobial stewardship and Clostridium difficile-<br>associated diarrhea. J Pharm Pract 2013;26:506-13. </p></li>
<li><p>Søes LM, Holt HM, Böttiger B et al. Risk factors for Clostridium difficile infection in the community: a case-control study among patients in general practice, Denmark, 2009-2011. Epidemiol Infect 27. sep 2013 (epub ahead of print).</p></li>
<li><p>Søes LM, Brock I, Persson S et al. Clinical features of Clostridium difficile infection and molecular characterization of the isolated strains in a cohort of Danish hospitalized patients. Eur J Clin Microbiol Infect Dis 2012;31:185-92. </p></li>
<li><p>Ludwig A, Sato K, Schirmer P et al. Concurrent outbreaks with co-infection of norovirus and Clostridium difficile in a long-term-care facility. Epidemiol Infect 2013;141:1598-603. </p></li>
<li><p>Lee DY, Chung EL, Guend H et al. Predictors of mortality after emergency colectomy for Clostridium Difficile colitis: an analysis of ACS-NSQIP. Ann Surg 2013: doi: 10.1097/SLA.0b013e31828a8eba</p></li>
<li><p>Marsh JW, Arora R, Schlackman JL et al. Association of relapse of Clostridium difficile disease with BI/NAP1/027. J Clin Microbiol 2012;50:4078-82. </p></li>
<li><p>Mascart G, Delmée M, Broeck JV et al. Impact of ribotype 027 on Clostridium difficile infection in a geriatric department. Eur J Clin Microbiol Infect Dis 2013;32:1177-82. </p></li>
<li><p>Bacci S, St-Martin G, Olesen B et al. Outbreak of Clostridium difficile 027 in North Zealand, Denmark, 2008-2009. Euro Surveill 2009;14:pii=19183. </p></li>
<li><p>Hebert C, Du H, Peterson LR et al. Electronic health record-based detection of risk factors for Clostridium difficile infection relapse. Infect Control Hosp <br>Epidemiol 2013;34:407–14. </p></li>
<li><p>Louie TJ, Miller MA, Crook DW et al. Effect of age on treatment outcomes in Clostridium difficile infection. J Am Geriatr Soc 2013;61:222-30. </p></li>
<li><p>Lavergne V, Beauséjour Y, Pichette G et al. Lymphopenia as a novel marker of Clostridium difficile infection recurrence. J Infect 2013;66:129-35. </p></li>
<li><p>van Nood E, Vrieze A, Nieuwdorp M et al. Duodenal infusion of donor feces for recurrent Clostridium difficile. N Engl J Med 2013;368:407-15. </p></li>
<li><p>Burke KE, Lamont JT. Fecal transplantation for recurrent Clostridium difficile infection in older adults: a review. J Am Geriatr Soc 2013;61:1394-8. </p></li>
<li><p>Pawar D, Tsay R, Nelson DS et al. Burden of Clostridium difficile infection in long-term care facilities in Monroe County, New York. Infect Control Hosp <br>Epidemiol 2012;33:1107-12. </p></li>
<li><p>Kim JH, Toy D, Muder RR. Clostridium difficile infection in a long-term care facility: hospital-associated illness compared with long-term care-associated illness. Infect Control Hosp Epidemiol 2011;32:656-60. </p></li>
<li><p>Forster AJ, Taljaard M, Oake N et al. The effect of hospital-acquired infection with Clostridium difficile on length of stay in hospital. Can Med Assoc J 2012;184:37-42. </p></li>
<li><p>Magalini S, Pepe G, Panuzi S. An economic evaluation of Clostridium difficile infection management in an Italian hospital environment. Eur Rev Med <br>Pharmacol Sci 2012;16:2136-41.</p></li>
<li><p>Bouza E. Consequences of Clostridium difficile infection: understanding the healthcare burden. Clin Microbiol Infect 2012;18:5-12. </p></li>
<li><p>DANMAP rapport 2012. www.danmap.org (6. nov 2013).</p></li>
<li><p>Hansen DS, Schumacher H, Hansen F et al. Extended-spectrum <span class="char char_VP_Symbol">β</span>-lactamase (ESBL) in Danish clinical isolates of Escherichia coli and Klebsiella pneumoniae: prevalence, <span class="char char_VP_Symbol">β</span>-lactamase distribution, phylogroups, and co-resistance. Scand J Infect Dis 2012;44:174-81. </p></li>
<li><p>Skov R, Hansen DS. MRSA og ESBL er fortsat stigende i samfundet og ved hospitalsassocierede udbrud. Ugeskr Læger 2011;173:2869-72. </p></li>
<li><p>Ku NS, Kim YC, Kim MH et al. Risk factors for 28-day mortality in elderly patients with extended-spectrum <span class="char char_VP_Symbol">β</span>-lactamase (ESBL)-producing Escherichia coli and Klebsiella pneumoniae bacteremia. Arch Gerontol Geriatr 8. aug 2013 (epub ahead of print).</p></li>
<li><p>Hetem DJ, Westh H, Boye K et al. Nosocomial transmission of community-associated methicillin-resistant Staphylococcus aureus in Danish hospitals. <br>J Antimicrob Chemother 2012;67:1775-80. </p></li>
<li><p>Cheng VCC, Tai JWM, Wong ZSY et al. Transmission of methicillin-resistant Staphylococcus aureus in the long term care facilities in Hong Kong. BMC Infect Dis 2013;13:205. </p></li>
<li><p>Vejledning om forebyggelse af spredning af MRSA. København: Sundhedsstyrelsen, 2012. </p></li>
<li><p>Bloch B. Hygiejne på tværs – tværsektorielt samarbejde omkring patient/borger med behov for infektionshygiejnisk bistand – hvordan løses opgaven? (MPH-afhandl). Göteborg: Nordic School of Public Health – NHV, 2012. </p></li>
<li><p>Sundhedsstyrelsen. Forebyggelsespakke – Hygiejne. København: Sundhedsstyrelsen, 2012. </p></li>
</ol>